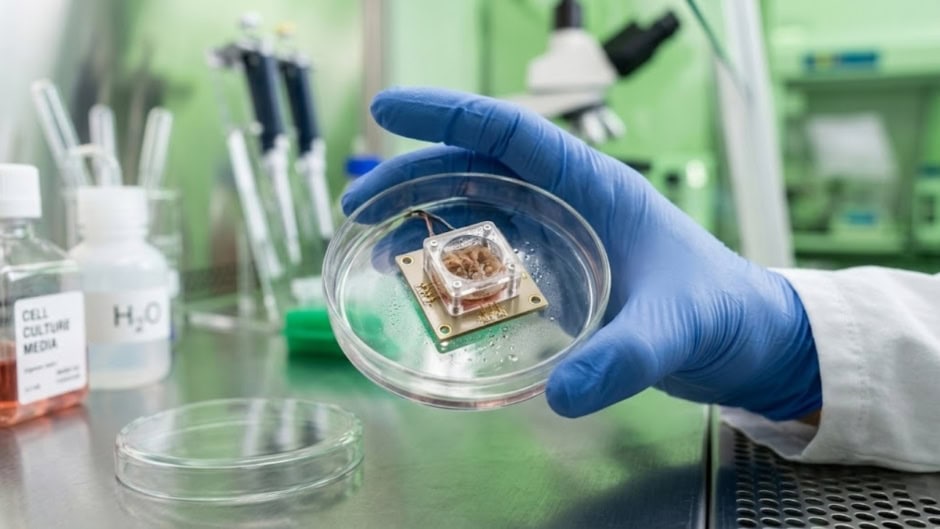
200000 Lab Grown Human Brain Cells Can Now Play Video Games

Australian biotechnology startup Cortical Labs trained clusters of lab-grown human brain cells to play the 1993 video game Doom. The experiment answers the long running technology question about whether this new form of “hardware” can run Doom. In this case the system is a biological computer powered by human neurons.
Researchers connected living neurons to software that converts gameplay into electrical signals. The system translates neural activity into in game controls. This allows the cells to move, react to enemies, and fire weapons during gameplay. The experiment expands the company’s earlier work and represents a new step in Synthetic Biological Intelligence.
The platform behind the experiment is called CL1. The system contains lab grown human neurons placed on an electrode array with 59 electrodes built into metal and glass. The neurons originate from adult donor skin or blood samples that researchers reprogram into stem cells before turning them into brain cells.
An internal life support system regulates temperature, gas mixture, and waste filtration to keep the neurons alive. The system can maintain the cells for up to six months. Cortical Labs also developed a biological operating system called biOS that allows software to interact directly with the neural network.
The project builds on earlier experiments from 2022. At that time the team trained clusters of human brain cells to play the simple arcade game Pong. Training those earlier biological systems required more than eighteen months of development work.
Engineers later solved a major challenge involving visual input. Because the neurons cannot see a screen, researchers converted visual game information into electrical stimulation patterns. The neurons respond to these signals and generate activity that controls movement and actions in the game.
The system currently performs at a beginner level. Researchers say the neurons show adaptive behavior and learn through feedback signals that reward successful actions.
Scientists say the experiment demonstrates real time learning in biological systems. The work also raises new ethical questions as experiments with brain organoids continue to expand.